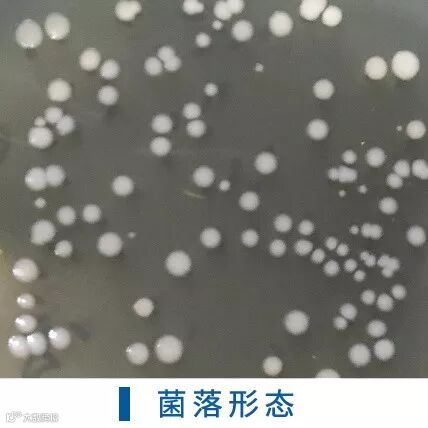
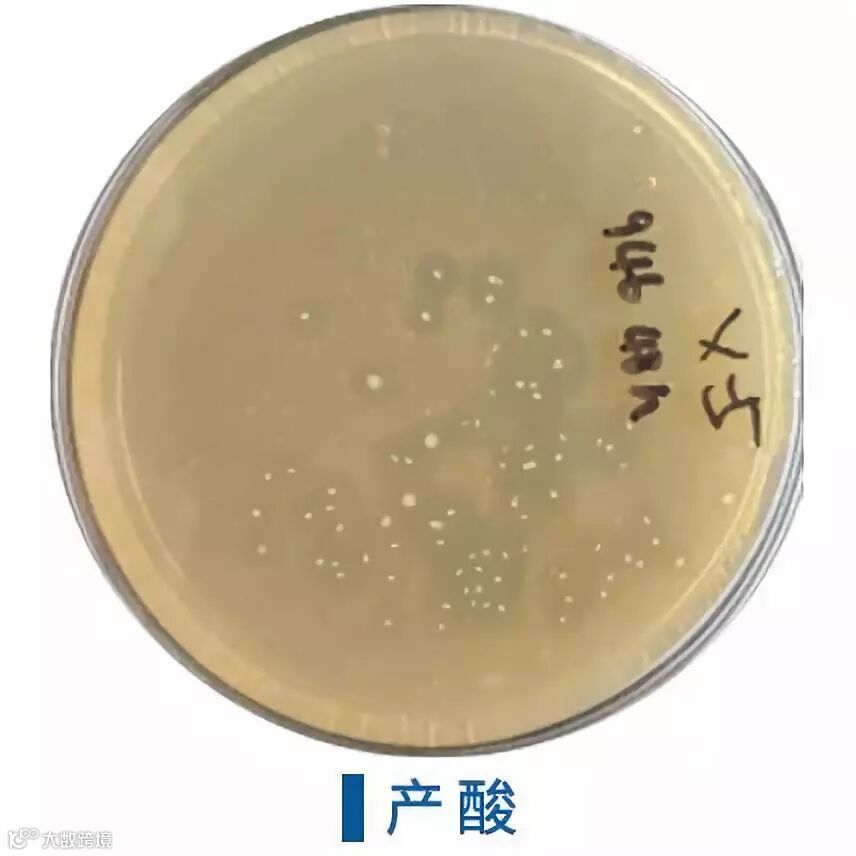

01
凝结芽孢杆菌
近年来,乳酸菌在饲料中应用优势得到了越来越多专业人士认可,但因乳酸菌具有抗逆性差、难保存等缺点,从而限制了其在养殖行业的广泛应用。博仕奥凝结芽孢杆菌是博仕奥集团经过多年的研究,开发出的一种具有抗逆性强、易保存、产乳酸等优点的新型活菌制剂。
02
凝结芽孢杆菌的特性
凝结芽孢杆菌是革兰氏阳性菌,兼性厌氧,硬壁菌门,菌落圆形,白色,边缘整齐,表面湿润光滑,显微镜下菌体呈杆状,两端钝圆,芽孢端生,没有鞭毛
最适生长温度为37℃-50℃
最适生长pH值为6.5-7.0
能产生凝结素,抑制有害菌生长

03
凝结芽孢杆菌抗逆性表现
01
耐温:凝结芽孢杆菌经80℃ 湿热处理10min,存活率95%以上
02
耐酸:凝结芽孢杆菌在pH 2.0的酸性条件下培养6 h存活率可达到48.2%;将其置于pH 2.42的酸性条件下存放一年后,仍还有很高的菌存活率
03
耐受胆盐:据研究发现在0.9%胆盐浓度下,培养24 h后其存活率达到78.3%,0.3%的条件下其存活率可达到84.3%
04
产乳酸及凝结素抑制病原菌: 凝结芽孢杆菌产乳酸和一些低分子量胺类混合物对大肠埃希氏菌、沙门氏菌志贺氏菌和变形杆菌等常见的肠道病原菌有一定抑制作用;同时凝结芽孢杆菌还能分泌抗菌肽物质—凝结素。凝结素是一种由44个氨基酸残基组成的蛋白质,带正电荷 ,具阳离子特性。含有两性区或疏水区。细菌的细胞膜含有磷脂,其细胞壁呈酸性,带正电荷的凝结素能穿透靶细胞的细胞膜直接将致病菌杀死
博仕奥凝结芽孢杆菌作为新型产乳酸、抗逆性强的微生态制剂,能够完全替代乳酸菌使用,在饲料行业具有广阔的应用前景,将为饲料企业创造更大的价值!

想了解更多?
那就赶紧来关注我们

长按二维码 关注我们
详细信息,请与我们联系
020-32038977



